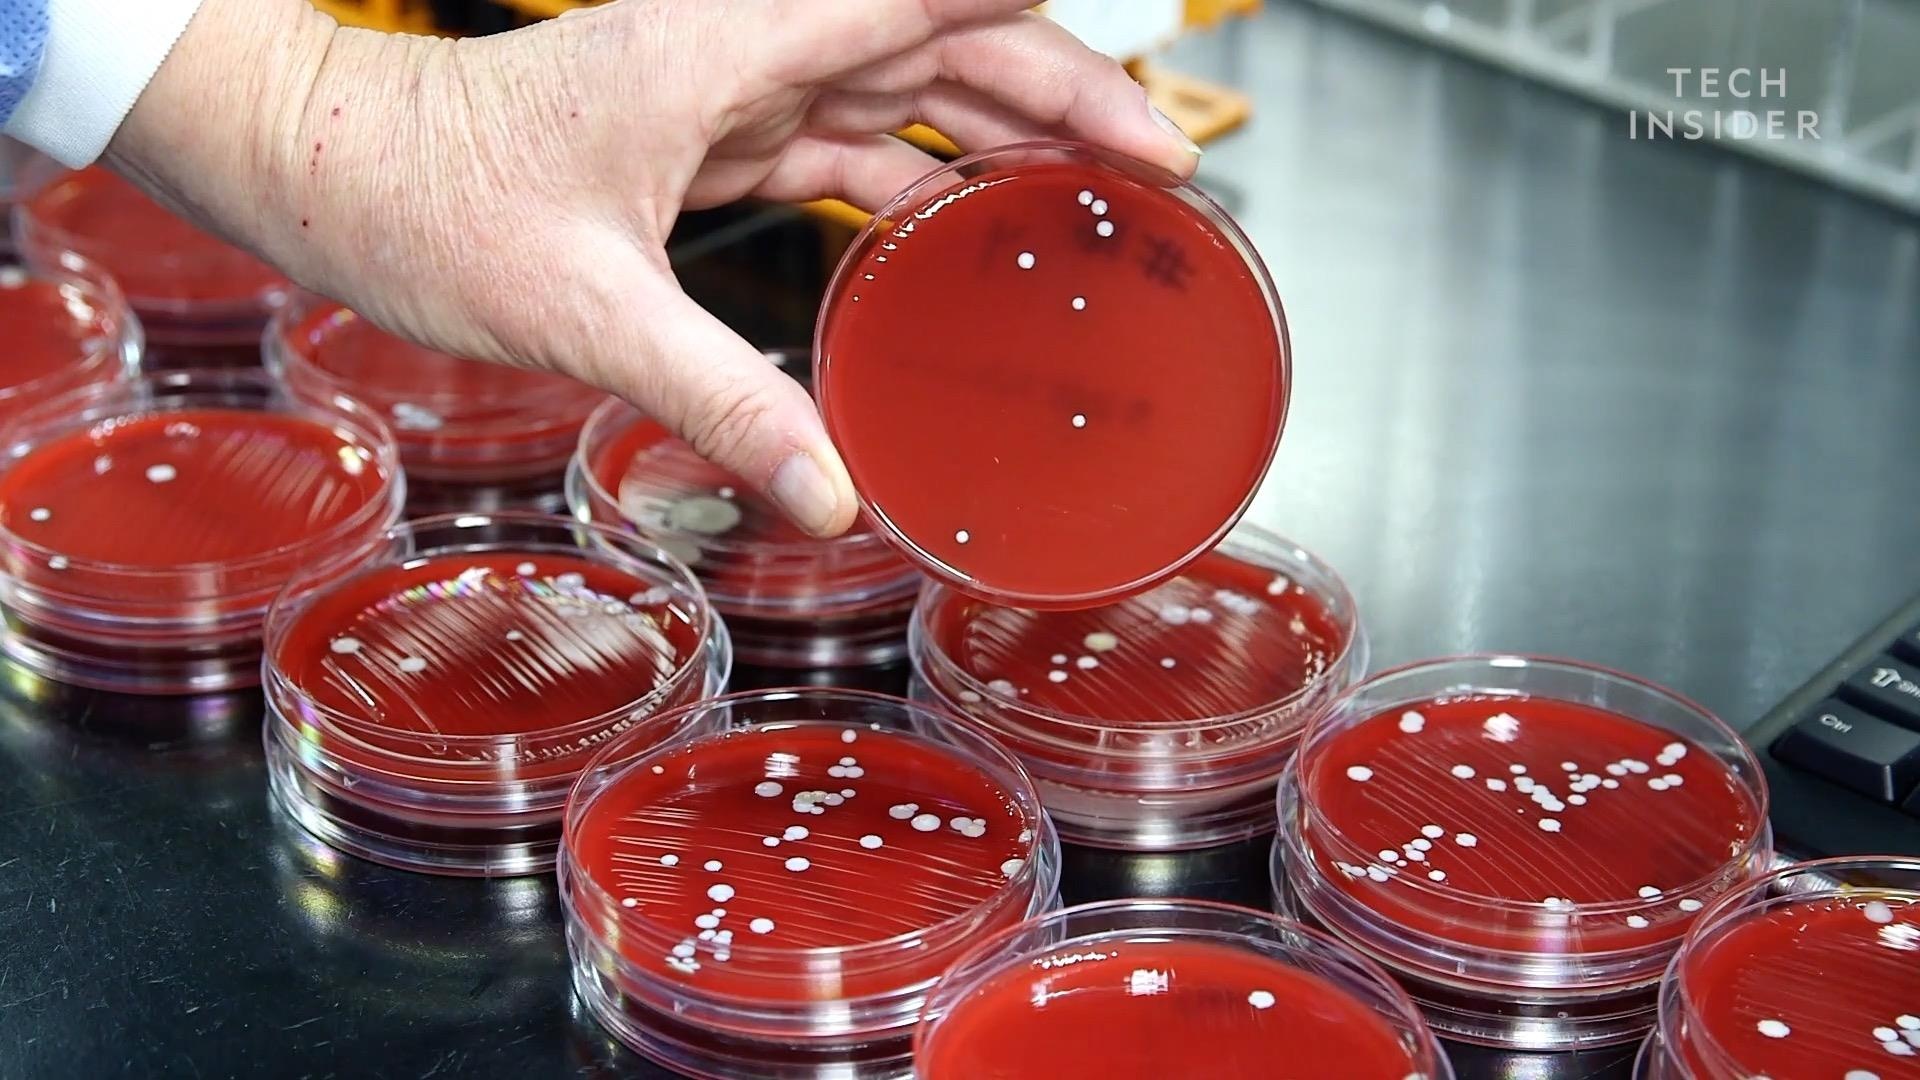
vì sao bạn không nên chia sẻ tai nghe với người khác ảnh 2 vi sao ban khong nen chia se tai nghe voi nguoi khac anh 2

Bạn đã bao giờ cho người khác mượn tai nghe của mình, hoặc ngược lại? Nếu có, những gì bạn chia sẻ không chỉ là chất âm của chiếc tai nghe, mà có thể là cả vi khuẩn bám trên nó. Sử dụng chung tai nghe không khác gì dùng chung… tăm bông ngoáy tai.
Dù bạn không đưa tai nghe vào sâu bên trong như bông ngoáy tai, ráy tai vẫn có thể bám vào tai nghe, và dính vào tai người khác khi bạn chia sẻ tai nghe.
![]() |
| Chia sẻ tai nghe rất lãng mạn, nhưng có thể khiến bạn lây vi khuẩn của người khác. Ảnh: Backgrid. |
Để biết những nguy cơ có thể xảy ra khi chia sẻ tai nghe, Business Insider đã thử nghiệm với 22 cặp tai nghe để tìm ra những gì có thể ẩn giấu bên trong chúng. Những thứ bám lại trên tai nghe được lấy mẫu và đem đến phòng thí nghiệm vi sinh của đại học Columbia để xét nghiệm.
“Lỗ tai của bạn là một nơi tối tăm, ẩm ướt, ấm áp. Vì vậy đó là một nơi sinh trưởng hoàn hảo. Nếu bạn đưa vi khuẩn hoặc nấm vào bên trong tai của mình, vi khuẩn có thể phát triển nhờ vào chính cấu tạo của lỗ tai”, bác sĩ Sujana Chandrasekhar chuyên khoa tai, mũi, họng chia sẻ.
Sau khi để vi khuẩn lên các đĩa nuôi vi khuẩn trong 3 ngày, phòng thí nghiệm đã thu lại kết quả khá bất ngờ. Không có loại vi khuẩn nào đáng sợ như kiểu tụ cầu vàng kháng methicillin (MRSA) hay vi khuẩn E. coli có trong phân người, như kết quả mà phòng thí nghiệm tìm thấy trên smartphone nhiều người vào năm 2017.
![]() |
| Vi khuẩn trên tai có thể phát triển thành nấm hoặc trực khuẩn trong đất. Ảnh: Business Insider. |
Thay vào đó, thứ đáng sợ nhất họ tìm được là trực khuẩn (Bacillus), có thể tìm thấy trong đất. Ngoài ra, các vi khuẩn tìm thấy được là dạng tụ cầu có thể xuất hiện trên da. Nói cách khác, kết quả xét nghiệm cho thấy ráy tai cũng chỉ “bẩn” tương đương da người mà thôi.
“Tôi khá là sốc khi thấy kết quả không có thứ gì siêu bẩn, đáng sợ. Ai cũng có vi khuẩn trên da, và những gì thu được hầu hết là những vi khuẩn này”, bà Susan Whittier, Giám đốc phòng thí nghiệm vi sinh thuộc đại học Columbia chia sẻ.
“Dù vậy, chắc chắn tôi sẽ không chia sẻ tai nghe của mình với người khác, mặc dù những kết quả này cho thấy chúng ta thực sự không tìm thấy bất cứ điều gì khác thường. Dù nó là những loại vi khuẩn bình thường, tôi vẫn muốn giữ vi khuẩn của tôi cho riêng mình”, bà Whittier nói thêm.
Tuy nhiên, một số mẫu thử cũng sản sinh ra nấm, thứ có thể khiến tai bị nhiễm trùng. Do đó, bạn vẫn nên làm sạch tai nghe trước khi chia sẻ với người khác.